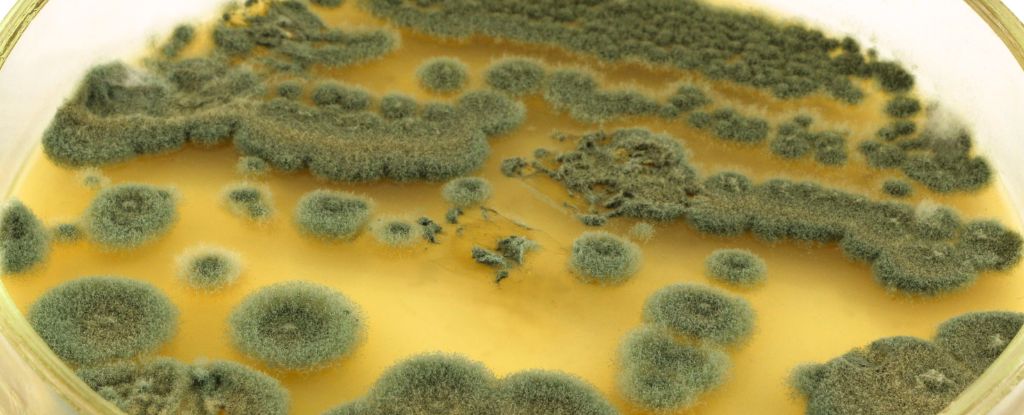
Featured image for Many Americans Mistakenly Believe They're Allergic to Penicillin

Brazil's Bolsonaro Receives Medical Treatment and Supports Son's Presidential Bid
Brazil's former president Jair Bolsonaro received a non-surgical medical procedure to treat his chronic hiccups, which had persisted for months, after undergoing recent hernia surgery. The treatment, targeting his phrenic nerve, was successful, and he is expected to return to his detention at the federal police headquarters to continue serving his sentence for coup plot involvement. Bolsonaro remains a significant political figure amid ongoing legal and political developments in Brazil.